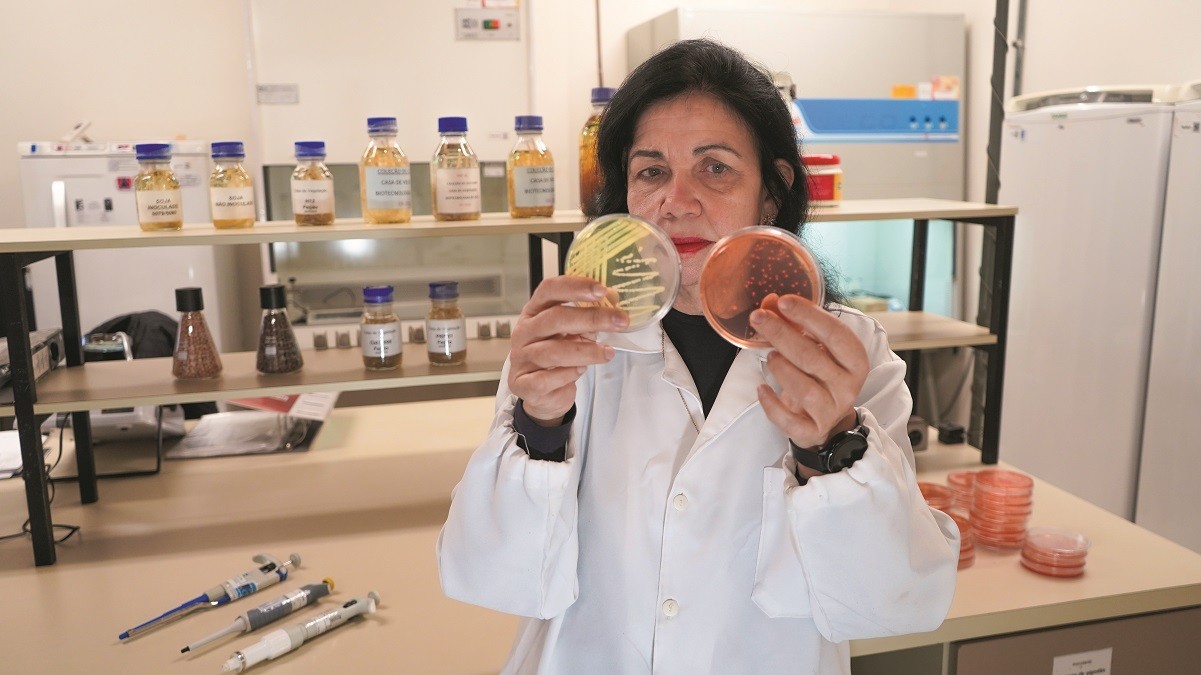

Mariangela Hungria, da Embrapa Soja, é a primeira mulher do Brasil a ser laureada pelo Prêmio Mundial da Agricultura A cientista brasileira Mariangela Hungria irá receber o Prêmio Mundial de Alimentação – World Food Prize (WFP). A pesquisadora da Embrapa Soja será laureada por sua contribuição ao desenvolvimento de insumos biológicos para a agricultura. O anúncio de sua nomeação ocorreu na noite desta terça-feira (13/5), e a entrega será em outubro, em Des Moines (EUA), na sede da Fundação World Food Prize, criada por Norman Bourlaug, conhecido como o “pai da Revolução Verde”.
Leia também
“Estou incrédula ainda e imensamente feliz, pois é uma grande honra ter um reconhecimento mundial. Acredito que minha persistência de que a produção de alimentos é essencial, mas deve ser feita com sustentabilidade somada a uma vida dedicada à busca por altos rendimentos via uso de biológicos ajudou para o reconhecimento”, destaca a pesquisadora.
Para ela, a premiação condecora o empenho da pesquisa brasileira, que cada vez mais tem se tornado referência no mundo. “O Brasil é líder na pesquisa de agricultura tropical, e é onde se pode aumentar os cultivos de maneira sustentável”, diz à Globo Rural.
Ela é a primeira mulher brasileira a ser laureada. Antes, apenas três representantes do Brasil receberam a nomeação. Em 2006, o ex-ministro da Agricultura, Alysson Paolinelli e o agrônomo Edson Lobato dividiram o prêmio com o colega estadunidense A. Colin McClung, pelo trabalho de desenvolvimento da agricultura na região do Cerrado.
Em 2011, dois ex-presidentes – Luiz Inácio Lula da Silva, do Brasil, e John Kufuor, de Gana, foram os escolhidos pelo trabalho com a erradicação da fome em seus países.
Anualmente, o prêmio reconhece personalidades que contribuem para o aprimoramento da qualidade e da disponibilidade de alimentos no mundo, por isso é conhecido como o “Nobel” da Agricultura e Alimentação, uma vez que essa categoria não é contemplada nas categorias oficiais do Nobel.
Contribuições
Para a pesquisadora, por muitos anos, o conceito predominante era o de produzir alimentos para acabar com a fome no mundo, no entanto, seu trabalho sempre esteve pautado na produção de alimentos de forma sustentável. “Hoje, percebo uma crescente demanda global por maior produção e qualidade de alimentos, mas com sustentabilidade — reduzindo a poluição do solo e da água, e diminuindo as emissões de gases de efeito estufa”, ressalta.
“Minha abordagem busca “produzir mais com menos” — menos insumos, menos água, menos terra, menos esforço humano e menor impacto ambiental”, sempre rumo a uma agricultura regenerativa, reforça.
A pesquisadora receberá o prêmio de US$ 500 mil pelo trabalho de aplicação de processos microbiológicos para a melhoria, de forma sustentável, da nutrição, rendimentos e produtividade das culturas agrícolas.
Este ano, Mariangela também foi primeiro lugar em Ciências das Plantas e Agronomia e segundo lugar em Microbiologia na lista de melhores cientistas brasileiros da Research.com, conhecida por publicar rankings e dados de universidades e institutos públicos e privados globais.
Evolução da pesquisa em biológicos
“Quando eu fazia agronomia, a gente vivia os reflexos da Revolução Verde, o que foi maravilhoso, pois tirou milhões de pessoas da fome, mas era um melhoramento com base em químicos, especialmente em fertilizantes nitrogenados”, lembra.
Ao mesmo tempo, ela vê a evolução do Brasil na pesquisa de biológicos, porque, se nos anos 1970 e 1980, a visão era que jamais se conseguiria fazer uma agricultura em larga escala à base de biológicos, ao longo do tempo o diferencial brasileiro foi procurar biológicos que provassem ao agricultor a vantagem de rendimento, o que ela define como sua principal persistência no campo acadêmico.
Mariangela conversou com a reportagem da Globo Rural em São Paulo
Globo Rural/Isadora Camargo
“Conseguimos ser o maior produtor, maior exportador e o maior de todos do mundo em contribuição biológica com as bactérias que ajudam a fixar nitrogênio na soja”, defende.
Segundo Mariangela, em geral, o agricultor brasileiro é bastante receptivo para adotar inovações nas lavouras e isso ajudou no avanço da utilização de microrganismos na cultura da soja, depois de cinco décadas de pesquisa. Outro diferencial no Brasil é que, mesmo com poucas pessoas fazendo pesquisa, aumentou o número de hectares para serem tratados com as tecnologias estudadas.
Para ela, os próximos passos dos estudos com bioinsumos estarão concentrados em soluções oriundas de microrganismos do solo, já que atualmente só se conhece 1% destas bactérias e fungos.
Entraves geopolíticos
Como muitas parcerias de pesquisa na Embrapa são internacionais, a pesquisadora avalia que as tensões geopolíticas protagonizadas pelo governo dos Estados Unidos dificultam a previsibilidade de novos acordos de colaboração no futuro. “Politicamente, está tudo muito instável. Nós tínhamos vários projetos e intenções de colaboração com os EUA, que agora estão suspensos”, afirma.
Por outro lado, ela considera que há boas surpresas em relação ao interesse de diversos países na pesquisa sobre bioinsumos realizada no Brasil, em especial na Europa. Segundo Mariangela, que vem sendo procurada por estudiosos europeus, o interesse se reforça em particular pelo interesse da União Europeia em proteína vegetal e, aí, a soja tratada com biológicos entra em cena.
Currículo extenso em microbiologia
Mariangela Hungria trabalha na Embrapa Soja, em Londrina (PR), desde julho de 1981, onde também iniciou a carreira de professora na Universidade Estadual de Londrina (UEL). Mas sua imersão na pesquisa sobre microbiologia e fixação de nitrogênio no solo começou na graduação.
Formada em engenharia agronômica na Escola Superior de Agricultura “Luiz de Queiroz” (Esalq-USP), em 1979, ela conta que o sonho de ser cientista e trabalhar com micróbios começou na infância.
Desde o início da carreira acadêmica, mergulhou no tema de fixação biológica do nitrogênio, introduzida pela Dra. A.P. Ruschel, com quem cursou o mestrado em Solos e Nutrição de Plantas até 1981. Mariangela é doutora em Ciência do Solo pela Universidade Federal Rural do Rio de Janeiro (UFRRJ), pós-doutora em microbiologia na Universidade de Cornell (EUA) e em fitoquímica e sinalização molecular plantas-microrganismos na Universidade da Califórnia (EUA), além de ter realizado um terceiro PhD na Universidade de Sevilha (Espanha).






